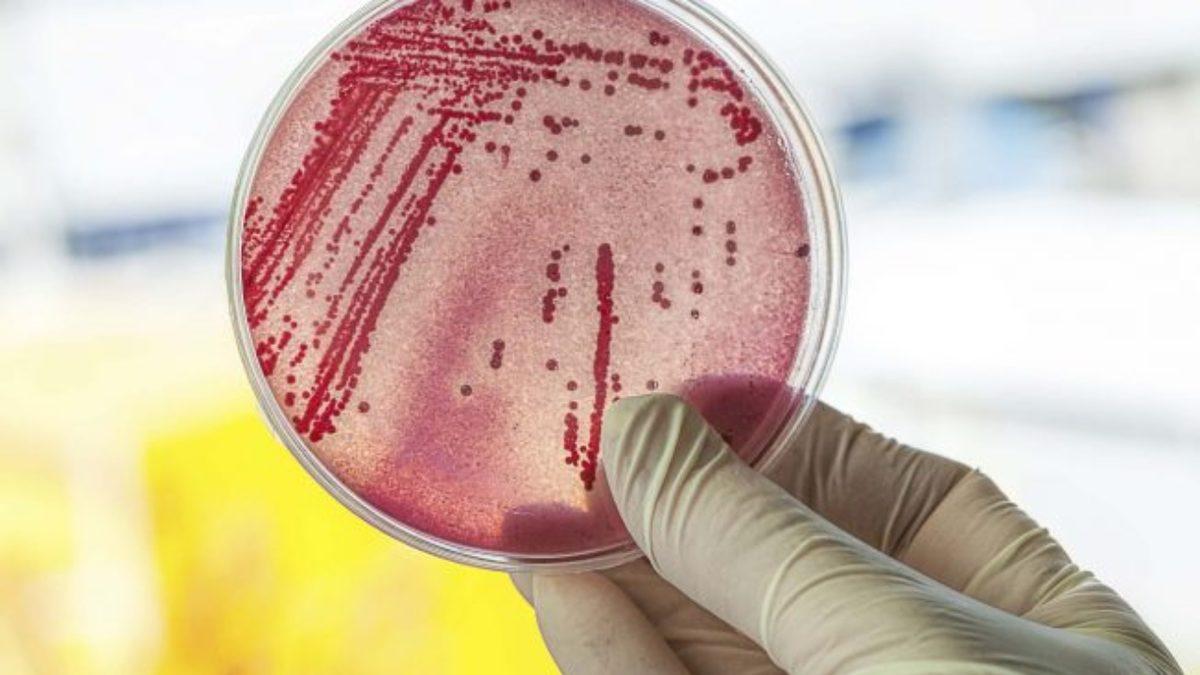
Japonya, Et yiyen Bakteri İstilâsı Altında: Ölüm Riski Çok Yüksek!

Streptokokal toksik şok sendromu (STSS), A grubu streptokokların neden olduğu, şok ve organ yetmezliği ile kendini belli eden ağır bir klinik sorundur. Bu durum ortaya çıktığında ateş, deri döküntüsü, karın ağrısı, halsizlik, ani ateş, baş dönmesi gibi sorunlar belirebiliyor. A grubu streptokoklar, et yiyen bakteri olarak da biliniyor.
Japonya Sağlık Bakanlığı'ndan yapılan açıklamaya göre bu yıl tam 977 vaka kayıtlara geçerken ölümcüllük oranı ise yüzde 30'a yükselmiş durumda. Salgından en çok etkilenenler arasında ise 50 yaşın üzerindeki bireylerin yer aldığı belirtiliyor. 1999'dan beri kaydı tutulan vakaların rekoru geçen yıl 941 ile kırılmışken bu yıl o rekor şimdiden geride kalmış durumda.
Ölüm oranları yükseliyor
Geçtiğimiz yıl Japonya'da STSS nedeniyle hayatını kaybeden kişi sayısı 97 olarak açıklanmıştı. STSS, özellikle enfeksiyonun ilk 48 saatinde oldukça öldürücü olabilen bir hastalık. GAS bakterilerinin ürettikleri bir zehir nedeniyle toksik şoka neden olabiliyorlar. Bu şok sonucunda da organlar faaliyetlerini yerine getiremiyor.
Uzmanlara göre STSS oldukça ölümcül olabilen bir durum ve her on hastadan üçü bu nedenle hayatını kaybediyor. Oldukça hızlı ilerleyen bu enfeksiyon, hemen tedavi edilmezse ilk 48 saat içinde ölümcül olabiliyor. Özellikle kronik hastalıkları olanlar ve bağışıklık sistemi zayıf kişiler bu enfeksiyondan etkileniyor.
